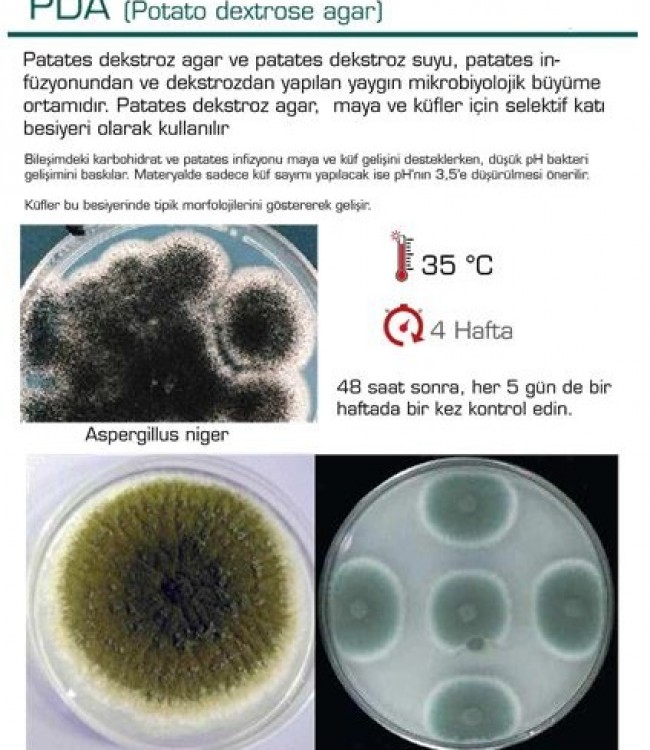
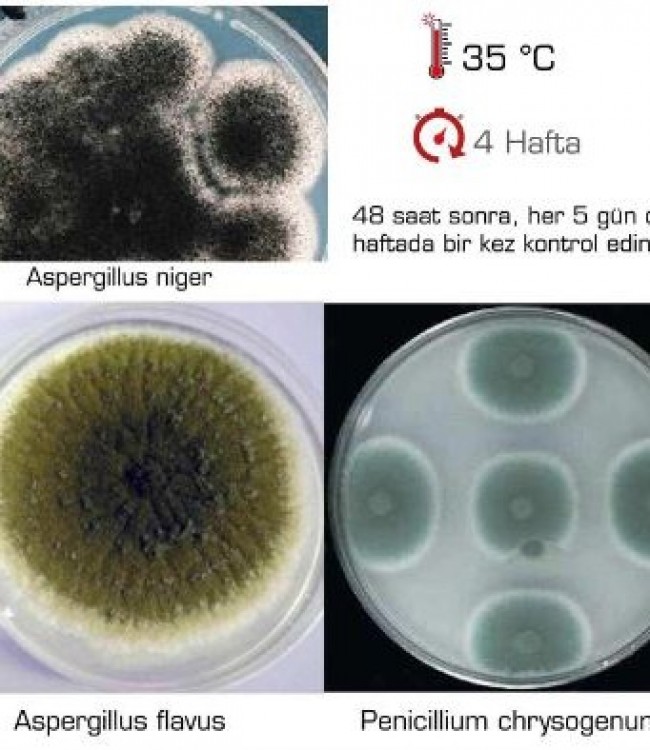

PDA (Potato Dextrose Agar)
PDA (Potato dextrose agar)
Patates dekstroz agar ve patates dekstroz suyu, patates infüzyonundan ve dekstrozdan yapılan yaygın mikrobiyolojik büyüme ortamıdır.
Patates dekstroz agar, maya ve küfler için selektif katı besiyeri olarak kullanılır
Bileşimdeki karbohidrat ve patates infizyonu maya ve küf gelişini desteklerkeni düşük pH bakteri gelişimini baskılar.
Materyalde sadece küf sayımı yapılacak ise pH'nın 3,5'e düşürülmesi önerilir.
Küfler bu besiyerinde tipik morfolojilerini göstererek gelişir.